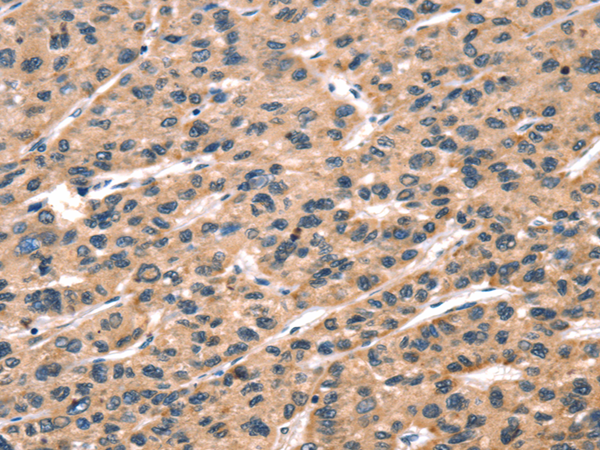

中文名稱:兔抗CGA多克隆抗體
英文名稱: Anti-CGA rabbit polyclonal antibody
別 名: HCG; LHA; FSHA; GPHa; TSHA; GPHA1; CG-ALPHA
相關(guān)類別: 一抗
抗 原: CGA
儲(chǔ) 存: 冷凍(-20℃)
宿 主: Rabbit
反應(yīng)種屬: Human
標(biāo) 記 物: Unconjugate
克隆類型: rabbit polyclonal
技術(shù)規(guī)格
|
Background: |
The four human glycoprotein hormones chorionic gonadotropin (CG), luteinizing hormone (LH), follicle stimulating hormone (FSH), and thyroid stimulating hormone (TSH) are dimers consisting of alpha and beta subunits that are associated noncovalently. The alpha subunits of these hormones are identical, however, their beta chains are unique and confer biological specificity. The protein encoded by this gene is the alpha subunit and belongs to the glycoprotein hormones alpha chain family. Two transcript variants encoding different isoforms have been found for this gene. |
|
Applications: |
ELISA, WB, IHC |
|
Name of antibody: |
CGA |
|
Immunogen: |
Fusion protein of human CGA |
|
Full name: |
glycoprotein hormones, alpha polypeptide |
|
Synonyms: |
HCG; LHA; FSHA; GPHa; TSHA; GPHA1; CG-ALPHA |
|
SwissProt: |
P01215 |
|
ELISA Recommended dilution: |
5000-10000 |
|
IHC positive control: |
Human breast cancer and human liver cancer |
|
IHC Recommend dilution: |
50-200 |
|
WB Predicted band size: |
13 kDa |
|
WB Positive control: |
HepG2 and 231 cell lysates |
|
WB Recommended dilution: |
500-2000 |

購(gòu)物車
購(gòu)物車 幫助
幫助
 021-54845833/15800441009
021-54845833/15800441009
